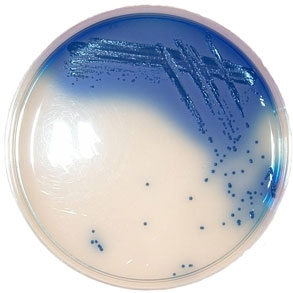

Лабораторное оборудование
Новые ответы на Вечные вопросы
Подписаться на рассылку
Компания СИМАС
Москва, Варшавское шоссе
д.125 стр.1
+7 (495) 980 - 29 - 37,
+7 (916) 942 - 65 - 95
info@simas.ru
Москва, Варшавское шоссе
д.125 стр.1
+7 (495) 980 - 29 - 37,
+7 (916) 942 - 65 - 95
info@simas.ru

Начаты поставки питательных сред компании LAB M (Великобритания).
16.04.2012
Компания СИМАС подписала эксклюзивный дистрибьюторский договор с компанией LAB M (Великобритания) — производителем широкого спектра сухих питательных сред для микробиологических исследований (порядка 230 наименований). Среды ЛАБ М являются одними из самых высококачественных в мире.
Компания LAB M пользуется высокой международной репутацией, имеет международные сертификаты менеджмента качества продукции ISO 9001:2000 и ISO 13485; её продукция отвечает также стандартам СЕ (Евросоюза).
Среды LAB M используются в 14 различных отраслях индустрии: для микробиологического контроля пищевых продуктов - молочных и мясных, пива, напитков, воды и др.; фармацевтических препаратов и косметических средств и т.п.
Для клинической микробиологии выпускается 11 хромогенных сред для быстрого выделения и предварительной идентификации сальмонелл, листерий, колиформных бактерий и др.
Компания LAB M пользуется высокой международной репутацией, имеет международные сертификаты менеджмента качества продукции ISO 9001:2000 и ISO 13485; её продукция отвечает также стандартам СЕ (Евросоюза).
Среды LAB M используются в 14 различных отраслях индустрии: для микробиологического контроля пищевых продуктов - молочных и мясных, пива, напитков, воды и др.; фармацевтических препаратов и косметических средств и т.п.
Для клинической микробиологии выпускается 11 хромогенных сред для быстрого выделения и предварительной идентификации сальмонелл, листерий, колиформных бактерий и др.

LAB 117. Dermatophyte Test Medium ( D.T.M.) - агар для выделения грибов-дерматофитов.
LAB 192-А. Селективная среда ORSIM для выделения стафилококков, устойчивых к оксациллину.
LAB 1116-A. Cелективный MLCB - агар для выделения сальмонелл.
LAB 217-A. Селективная среда с бенгальским розовым и хлорамфениколом для выделения грибов.
LAB 096-A. Cелективная среда TCBS для выделения холерных вибрионов.


















































